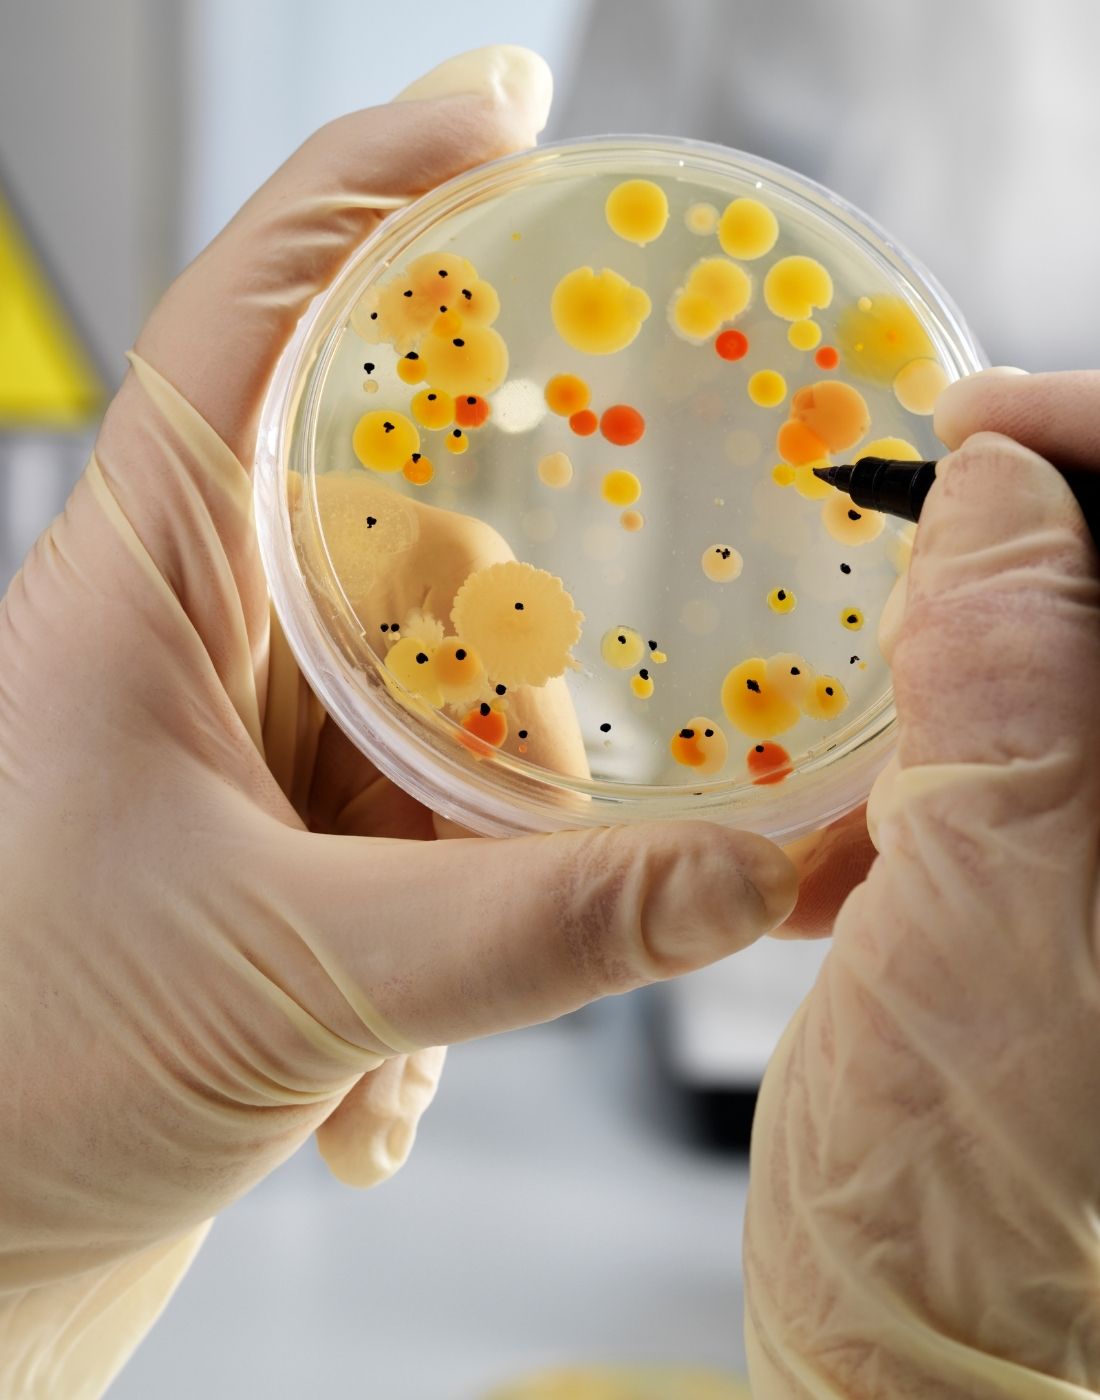

¿Por Qué Elegir Nuestra Homeopatía?

desde Austria, inglaterra, alemania y usa.
Ingredientes Importados
Los Medicamentos Homeopáticos Estimulan los Mecanismos de Autorregulación del Cuerpo para Iniciar el Proceso de Recuperación.

Libres de Efectos Secundarios

Remedios para Todas Etapas de Vida

Combinación de Medicamentos para Máximo Efecto
Descubre Remedios por Órganos



LA NECESIDAD DE SER CREATIVOS, INDEPENDIENTES Y REALIZAR UN PROYECTO DE IMPACTO EN LA SALUD, ESTABA LATENTE EN NOSOTROS DESDE HACE TIEMPO. QUERÍAMOS CREAR UNA SINERGIA ENTRE HOMEOPATÍA Y NUTRICIÓN MEDICINAL.